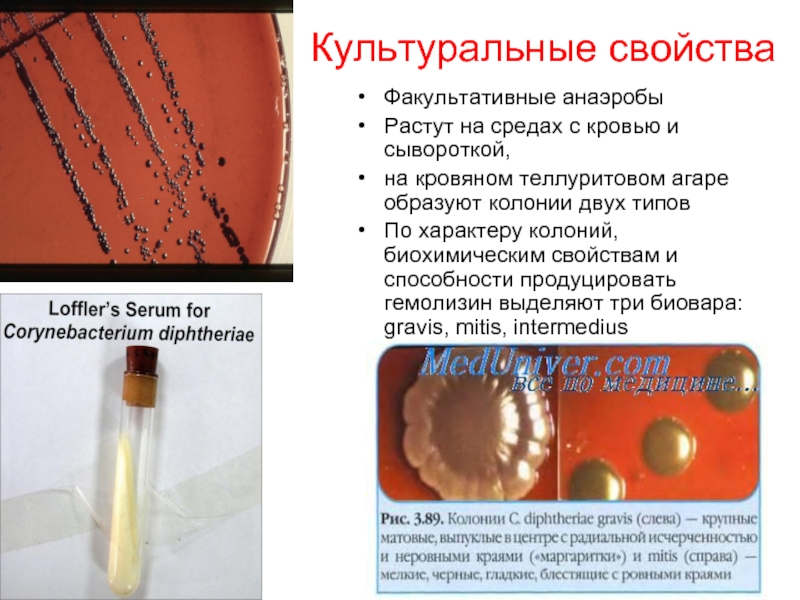

- Главная
- Разное
- Дизайн
- Бизнес и предпринимательство
- Аналитика
- Образование
- Развлечения
- Красота и здоровье
- Финансы
- Государство
- Путешествия
- Спорт
- Недвижимость
- Армия
- Графика
- Культурология
- Еда и кулинария
- Лингвистика
- Английский язык
- Астрономия
- Алгебра
- Биология
- География
- Детские презентации
- Информатика
- История
- Литература
- Маркетинг
- Математика
- Медицина
- Менеджмент
- Музыка
- МХК
- Немецкий язык
- ОБЖ
- Обществознание
- Окружающий мир
- Педагогика
- Русский язык
- Технология
- Физика
- Философия
- Химия
- Шаблоны, картинки для презентаций
- Экология
- Экономика
- Юриспруденция
Дифтерия презентация
Содержание
Слайд 2Морфология
C.diphtheriae окраска по Леффлеру
Грамположительные палочки с утолщениями на концах,
- располагаются
в виде V
- неподвижны
- многослойная клеточная стенка содержит миколовую кислоту, корд-фактор
- при окраске по Леффлеру и Нейссеру выявляются включения волютина на полюсах клетки
C.diphtheriae окраска по Нейссеру
C.diphtheriae окраска по Граму
Слайд 3Культуральные свойства
Факультативные анаэробы
Растут на средах с кровью и сывороткой,
на кровяном теллуритовом
агаре образуют колонии двух типов
По характеру колоний, биохимическим свойствам и способности продуцировать гемолизин выделяют три биовара: gravis, mitis, intermedius
По характеру колоний, биохимическим свойствам и способности продуцировать гемолизин выделяют три биовара: gravis, mitis, intermedius
Слайд 4Антигены
С. diphtheriae содержат в микрокапсуле К-антиген, позволяющий дифференцировать их на серовары
и группоспецифический полисахаридный антиген клеточной стенки